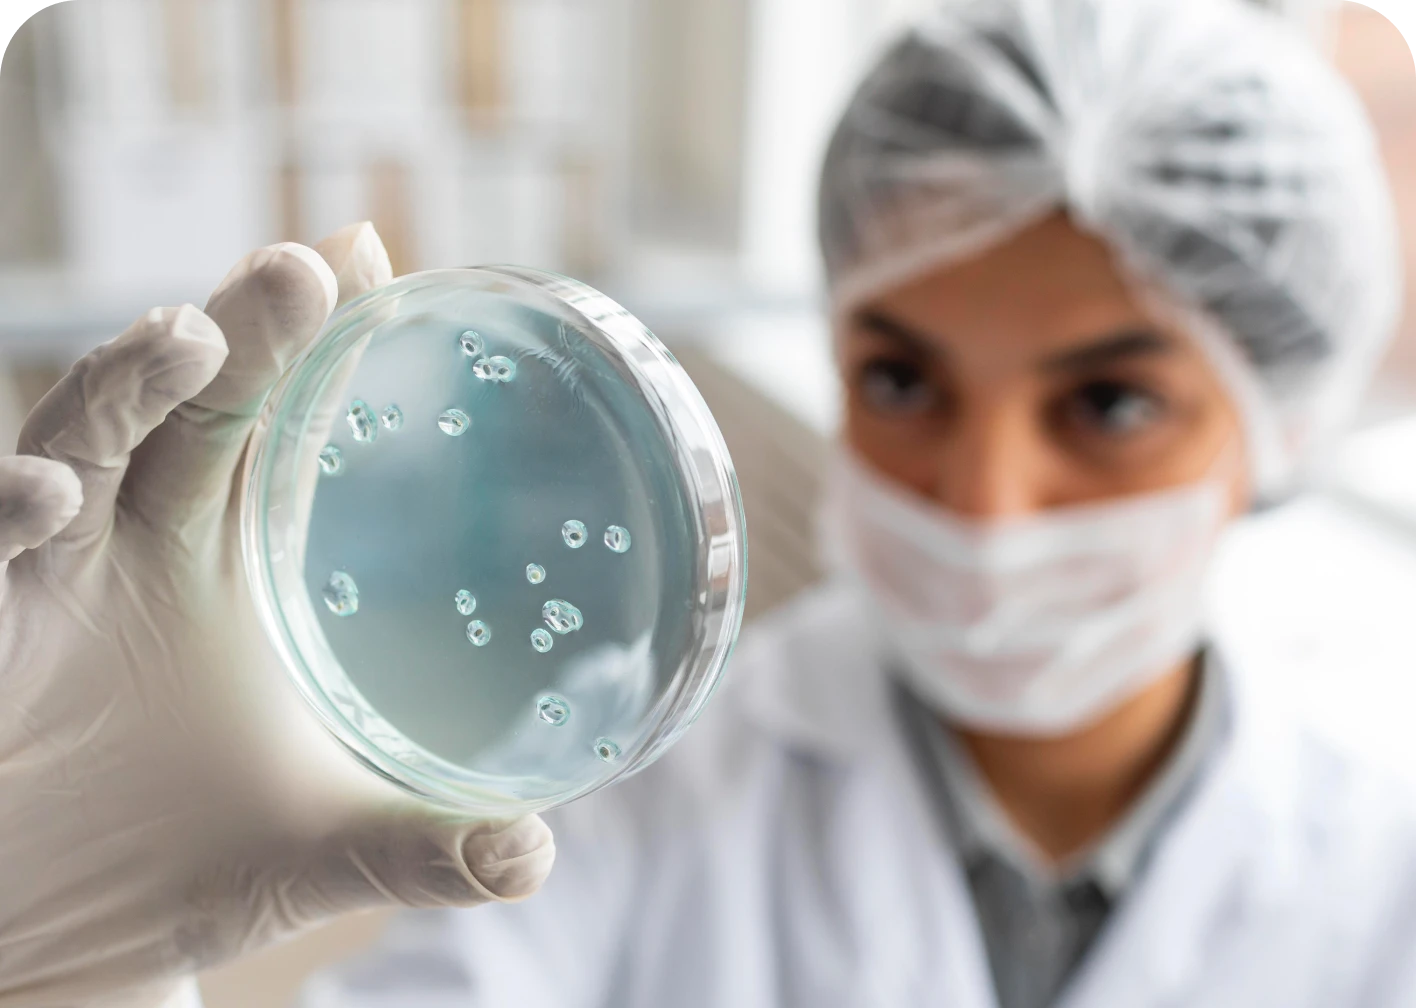

Diplomado Internacional en Enfermedades Infecciosas
$ COP 2.300.000
Actualización en el diagnóstico, prevención y tratamiento de enfermedades infecciosas, resistencia antimicrobiana y control epidemiológico.
Descripción
Formación clínica para enfrentar infecciones complejas con criterio y respaldo científico.
Productos relacionados
-

Diplomado Internacional en Cardiología
$ COP 2.300.000 Añadir al carritoDiplomado enfocado en diagnóstico y tratamiento de enfermedades cardiovasculares, técnicas de imagen cardiaca y manejo de patologías del corazón.
-

Diplomado Internacional en Anestesiología & Reanimación
$ COP 2.300.000 Añadir al carritoFormación especializada en técnicas anestésicas, manejo del dolor perioperatorio y reanimación cardiopulmonar avanzada para procedimientos quirúrgicos.
-

Diplomado Internacional en Medicina Intensiva
$ COP 2.300.000 Añadir al carritoCapacitación en el manejo de pacientes críticos, soporte vital avanzado, ventilación mecánica y monitorización hemodinámica en UCI.
-

Diplomado Internacional en Hematología
$ COP 2.300.000 Añadir al carritoProfundización en trastornos de la sangre, coagulación, anemias, leucemias y otras patologías hematológicas con enfoque clínico y de laboratorio.
$ COP 2.300.000
Detalles clave
- Duración: 8 meses
- Modalidad: Virtual
- Certificación: Avalado por UDIMA (30 ECTS)
- Acceso: Plataforma Blackboard 24/7 | Clases en vivo y grabadas
- Inscripciones abiertas | Cupos limitados
El valor de una formación que impulsa tu práctica
Cada programa combina contenidos esenciales, recursos audiovisuales, casos clínicos y evaluaciones progresivas que consolidan el aprendizaje.
Formación clínica para enfrentar infecciones complejas con criterio y respaldo científico.
Contenidos principales
- Microbiología
- Antibiótico terapia
- Infecciones cutáneas
- VIH
- Tuberculosis
- Infecciones en inmunodeprimidos
- Infecciones nosocomiales
- Parasitología
- Medicina del viajero
- Medidas preventivas
A quién está dirigido
- Médicos generales
- Internistas
- Profesionales de urgencias y hospitalización
Metodología de estudio
Una metodología creada por médicos que forman médicos.
Plataforma Blackboard 24/7
Clases grabadas 24/7 en Blackboard.
Material descargable
Material descargable y recursos aplicados.
Evaluaciones modulares
Evaluaciones modulares para medir tu progreso.
Estudio flexible y autogestionado
Adaptado a tu ritmo profesional.

Nuestros asesores expertos
te guiarán en cada paso...
Preguntas frecuentes
¿Cuál es la modalidad de estudio?
¿Recibo certificado al finalizar?
Da el siguiente paso en tu carrera médica
Tu crecimiento profesional comienza donde empieza tu actualización clínica.
